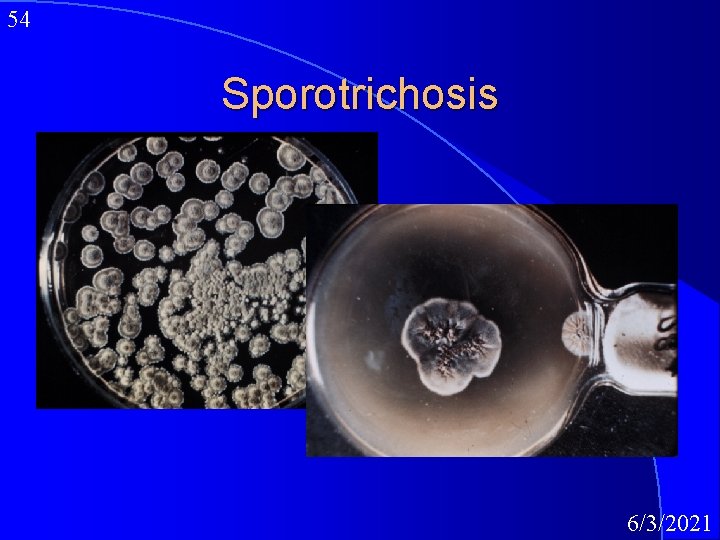
54 Sporotrichosis 6/3/2021

1 Medical Mycology Superficial Cutaneous and Subcutaneous Mycoses

1 Medical Mycology: Superficial, Cutaneous and Subcutaneous Mycoses Hugh B. Fackrell 6/3/2021

2 Mycoses & Mytoxicosis Mycoses: fungal infections l Mytoxicosis: intoxicaton l 6/3/2021

3 Fungal Disease Mycoses Colonization of the host l Mycotoxicosis: Intoxication l Hypersensitivity l 6/3/2021

4 Fungal Entry Rarely cause disease in healthy person l Commensal l – Candida albicans – Malasseza fufur l Underlying disorder – trauma – immunological deficiency – debilitating conditions 6/3/2021

5 Disease Mechanisms of Fungi Endogenous l Opportunistic l Iatrogenic – (physician induced) – e. g. indwelling lines catheters Exogenous l Opportunistic – inhalation l Superficial – Trauma hygiene l Cutaneous – trauma l Subcutaneous – trauma l Systemic – inhalation 6/3/2021

6 Fungal Dissemination l Breach in host defenses – endocrinopathies – immune disorders – iatrogenic l Must repair defect 6/3/2021

7 Host Defense Factors l l l Intact skin long chain fatty acids p. H Bacterial antagonism corneum stratum desiccated epithelial cell turnover rate (0. 5 kg/yr. ) l l Mucous membranes ciliated antimicrobials Immunological competence 6/3/2021

8 Fungal Infections l Opportunistic Infections l Superficial fungal infections l Cutaneous Mycoses l Subcutaneous Mycoses l Systemic Mycoses 6/3/2021

9 Structure of Skin 6/3/2021

10 Superficial Fungal Infections l Skin Infections – limited to Stratum corneum – do not penetrate deeper tissues l No inflammation 6/3/2021

11 Superficial mycoses Pityriasis versicolor l Black piedra l White piedra l tinea nigra l 6/3/2021

12 Black Piedra Superficial mycosis l Piedraia hortai l small firm black nodule l Surrounds hair shaft l 6/3/2021

13 White Piedra Superficial mycosis l Trichasporon beigelii l soft friable beige nodule l distal ends of hair shaft l 6/3/2021

14 Pityriasis Versicolor Common superficial mycosis l Superficial keratin layer l hypo or hyper pigmentation on skin of neck shoulders chest and back l Malassezia furfur 6/3/2021

15 Malassezia furfur 6/3/2021

16 Tinea Nigra Superficial mycosis l Phaeoannellomyces werneckii l silver nitrate type of stain l palm of hand l 6/3/2021

17 Cutaneous Mycoses Dermatophytoses l Dermatomycoses l 6/3/2021

18 Dermatophytoses Cutaneous Mycoses l Secrete keratinolytic enzymes which dissolve the skin protein KERATIN l Three genera l – Epidermophyton. – Microsporum, – Trichophyton l Anatomic specificity correlates with genus – -skin, hair, nails. 6/3/2021

19 Epidermophyton 6/3/2021

20 Microsporum 6/3/2021

21 Microsporum Ectothrix Spores on outside of hair follicle 6/3/2021

22 Microsporum 6/3/2021

23 Microsporum 6/3/2021

24 Microsporum Spores of Microsporum lie outside the hair shaft. This is known as ECTOTHRIX l Can be seen with an ultra violet lamp called a “Woods” light. Bright fluorescence. l Children are more susceptible than adults, because post pubertal sebum has fungistatic fatty acids especially M. audouinii l 6/3/2021

25 Microsporum audouinii, canis M. audouinii -Predominant species in temperate climates. Very contagious can cause epidemics Spread by barbers tools, seat head rests M. canis- Second most common- spread by kittens, pups - young animals 6/3/2021

26 Trichophyton 6/3/2021

27 Trichophyton 6/3/2021

28 Trichophyton 6/3/2021

29 Trichophyton 6/3/2021

Dermtaophytes: Tinea Infections 30 4 Tinea 4 capitis Tinea barba 4 Tinea corporis - Head, scalp, neck - Face - Body 4 Tinea. cruri - Groin, perineum 4 Tinea - Feet pedis 4 Tinea unguium -Nails TINEA means RINGWORM 6/3/2021

31 Tinea capitis Ringworm of the scalp-very contagiousespecially pre-pubertal children. Begins with small, itchy, scaling papule spreads peripherally makes a roundish lesion, Hair breaks off at scalp level, leaving a patch. 6/3/2021

32 Tinea Capitis 6/3/2021

33 6/3/2021

34 Tinea corporis Ringworm of the body, with annular lesions the centre is scaly and the periphery advancing circle of vesicles and papules. l Prefers areas that are hairy soon to become bare due to the fungus. l Associated with poor nutrition and hygiene but is also common in persons who frequent gymnasiums and pools. l 6/3/2021

35 6/3/2021

36 Tinea pedis - “Athletes foot”skin cracks between toes, maceration of tissue, desquamation, ulcerations, can spread whole bottom foot. Epidermophyton and Trychophyton. ~ 2% carry fungus no symptoms. men susceptible 6/3/2021

37 Tinea Pedis 6/3/2021

38 6/3/2021

39 Tinea cruris T. cruris- Groin, perineum, perianal region Epidermophyton floccosum or inguinale. Tight pants, perspiration, pubic contact. Epidermophyton and Trychophyton. ~ 2% carry fungus no symptoms. men susceptible 6/3/2021

40 Tinea Cruris Epidermophyton 6/3/2021

41 Tinea unguium Nails brittle thick, discoloured, grooved. Trichophyton rubrum most common in women aged 40 -50 Persistent very difficult to treat. Antibiotics cannot be effective. 6/3/2021

42 6/3/2021

43 Dermatomycoses Cutaneous fungal infections l inflammation l caused by opportunistic fungi l Candida spp l 6/3/2021

44 Cutaneous Mycoses: Treatment l Mild cases topical treatment 3% sulfur+3% salicylic acid ointment 1% crystal violet 1% iodine 1% tolnaftate 10% undecylenic acid miconazole haloprogin 6/3/2021

45 Cutaneous Mycoses Treatment Serious or stubborn cases Griseofulvin - 1 gram /day for 1 -3 months l This antimicrobial extracted from cultures of Penicillium griseofulvum in 1939 not used as a drug until 1959 6/3/2021
![46 Subcutaneous Mycoses Caused by trauma [puncture]and introduction of the fungus and bacteria. l 46 Subcutaneous Mycoses Caused by trauma [puncture]and introduction of the fungus and bacteria. l](http://slidetodoc.com/presentation_image_h2/4f633dfdb1a7af3ce5cb4d161d42b5fd/image-46.jpg)
46 Subcutaneous Mycoses Caused by trauma [puncture]and introduction of the fungus and bacteria. l Chromoblasomycosis l Phaeohypomycosis l Mycetoma l Sporotrichosis l 6/3/2021

47 Chromoblastomycosis Subcutaneous mycosis l verrucoid skin lesions l lower extremities l Histology l muriform cells- cross walls in two directions l no involement of bone tendon or muscle l 6/3/2021

48 6/3/2021

49 6/3/2021

50 Phaeohypomycosis Infections caused by dermatiaceous fungi l hyphal to yeast forms in tissue l l Dermatiaecous Fungi – melanin black fungi 6/3/2021

51 Mycetoma l Granulomatous local lesions – usually of the legs and feet – infect humans who have extensive contact with soil and foliage due to bare feet and legs. l Suppuration – small visible pigmented grains or granules – microcolonies l Destroys bone tendon and muscle 6/3/2021

52 Mycetoma caused by many organisms l Eumycotic mycetoma – fungal – USA Pseudallescheria boydii l Actinomycotic mycetoma – bacterial – USA Nocardia brailiensis l 6/3/2021

53 Sporotrichosis world wide-Sporothrix schenkii l ulcerative lesions at site on injured skin usually arm, spread to the regional lymph nodes. The high risk group, gardeners, farmers who work with wood/ soil. l Highly infectious on contaminated dressings to patients with wounds. l 6/3/2021
54 Sporotrichosis 6/3/2021

55 Sporotrichosis 6/3/2021

56 Sporotrichosis 6/3/2021

57 Treatment of sporotrichosis – topical potassium iodide – amphotericin B systemically. 6/3/2021
- Slides: 57